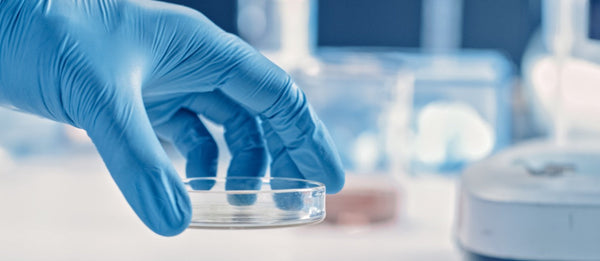

Science Labs
Mevol has always regarded product quality and scientific research as the company's pillars. Our labs invest heavily in a wide range of studies on ingredient, material, and device safety. We've set stringent production standards, by using almost 20 category-specific safety tests, nearly 30 international standard requirements, and over 50 ingredient indicators for reference.
Harm Reduction and Safety Research
Mevol believes in the power of science and innovation. We embrace cutting-edge, emerging technologies in the industry with an open mind so as to minimize the potential hazards of the products.


Our products are equipped with ultra-slim bionic film ceramic coil and use the industry's 1st nanoscale anti-corrosion layer. It makes the emission of heavy metals decreased by 78.6%
The emission of aldehydes and ketones decreased by
80.7 %



We test the composition of e-liquid across dozens of categories and hundreds of indicators to thoroughly evaluate the impacts of our vaping products on the consumers' health.
Overall harm reduction performance improved by
80.0 %


Harmless Materials, Clean and Hygienic Production Environment
From the selection of materials to production, Mevol partners with top supply chain teams in the industry. Our production site accommodates GMP 100,000 class cleanrooms and the products comply with EU RoHS standards. This fundamentally ensures product hygiene and safety.
Pursuit of Leading-edge Technologies
Mevol partners with top supply chain teams in the industry to launch the world's top vaping products based on the FEELM Air technology.


Equipped with a superabsorbent lock layer to firmly prevent e-liquid splashing during vaping, resulting in leakage-proof performance improved through the 2nd generation "Puzzle Leakage-proof" technology.
The leakage-proof performance improved by
237.0 %



Featuring a tailored taste release in different temperature zones and the original patented Taste-Lock™ technology.
The taste reproduction increased by
33.0 %

Excellent Testing Team to Drive Product Upgrades
Sensory Evaluation System
Worldwide blind tests are performed on each product before launch and evaluation is carried out from four dimensions: sight, taste, smell and touch.

Taste Evaluation Model
The model covers 51 indicators of taste, smell, aroma and strength, mapped to the sensations of body organs such as the mouth, tongue, nose and throat during vaping. This helps us establish a comprehensive cognition system for a stunning taste experience.